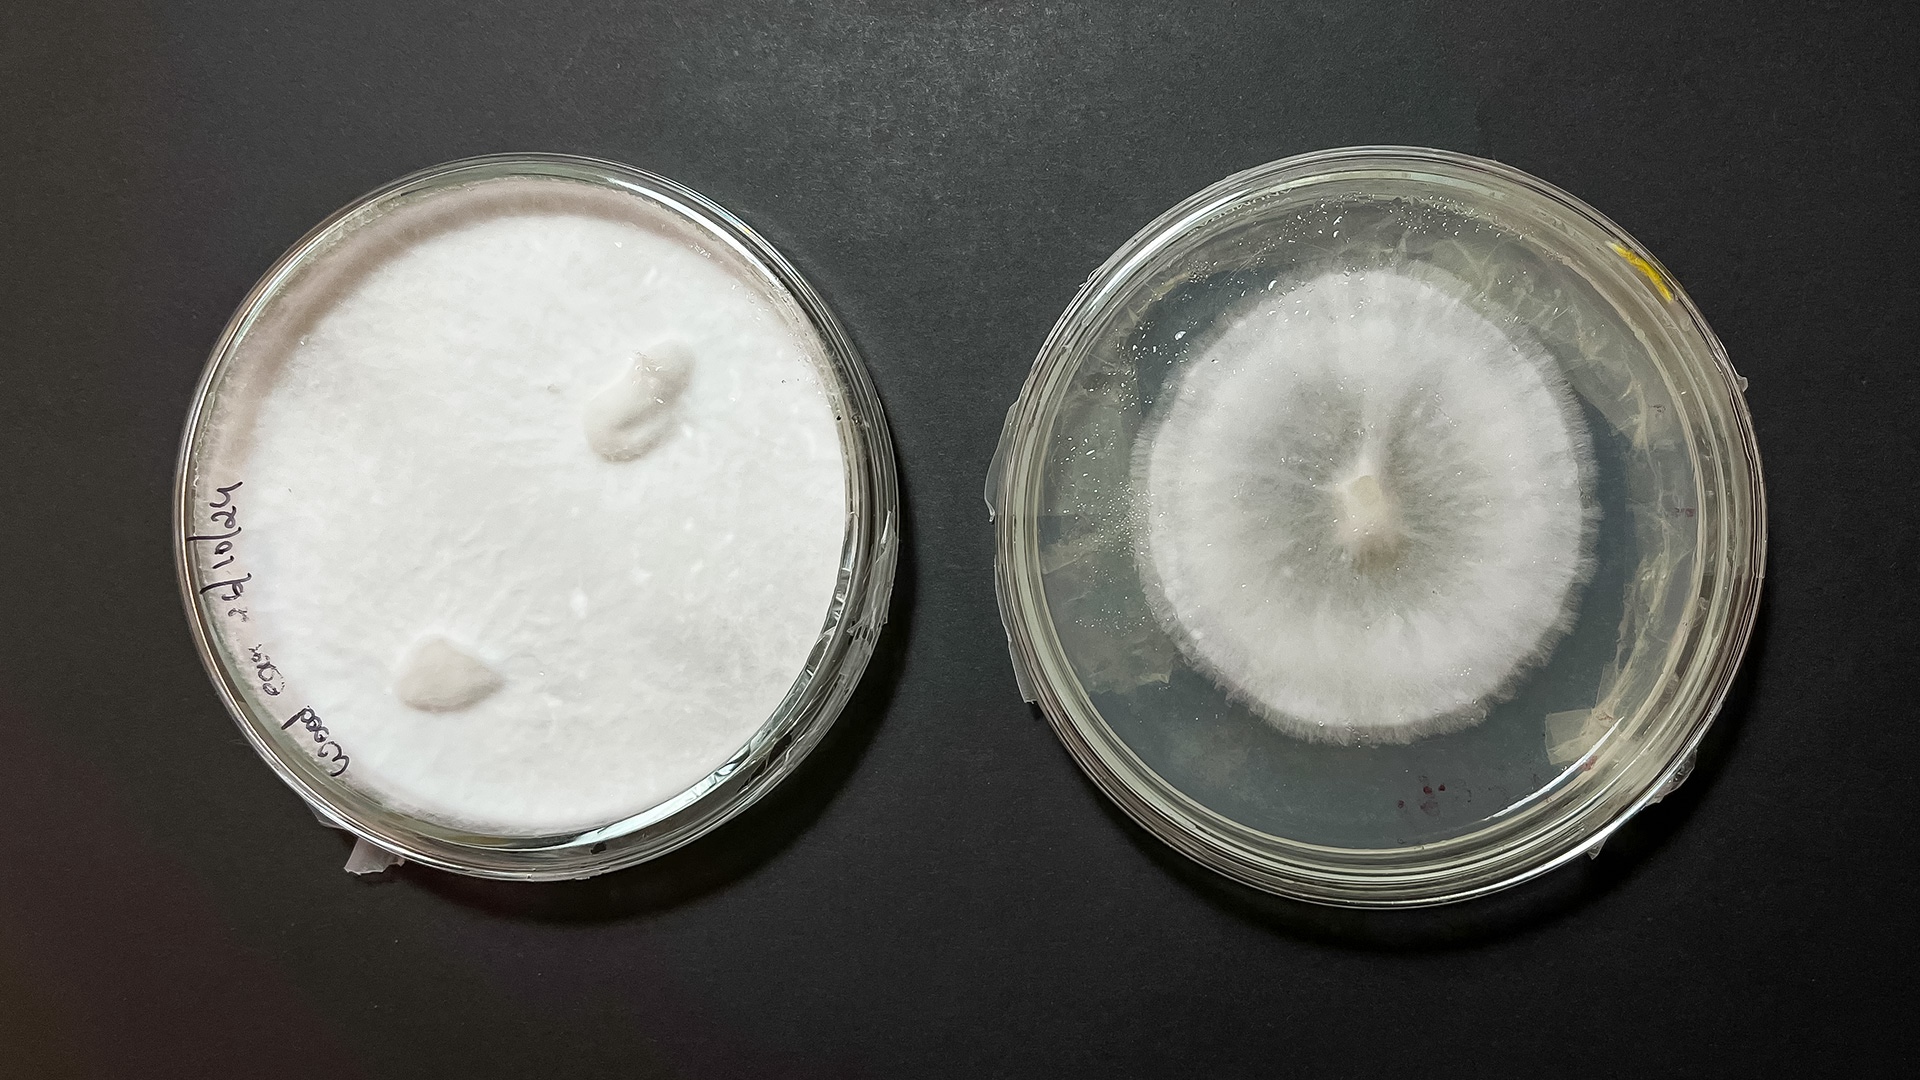
Two petri dished show mycelium growth: The one on the left is from a woodear fungi and is mostly white with two mushroom-like strucutres emerging from it, and the other one is circular mycelium from a reishi fungi.
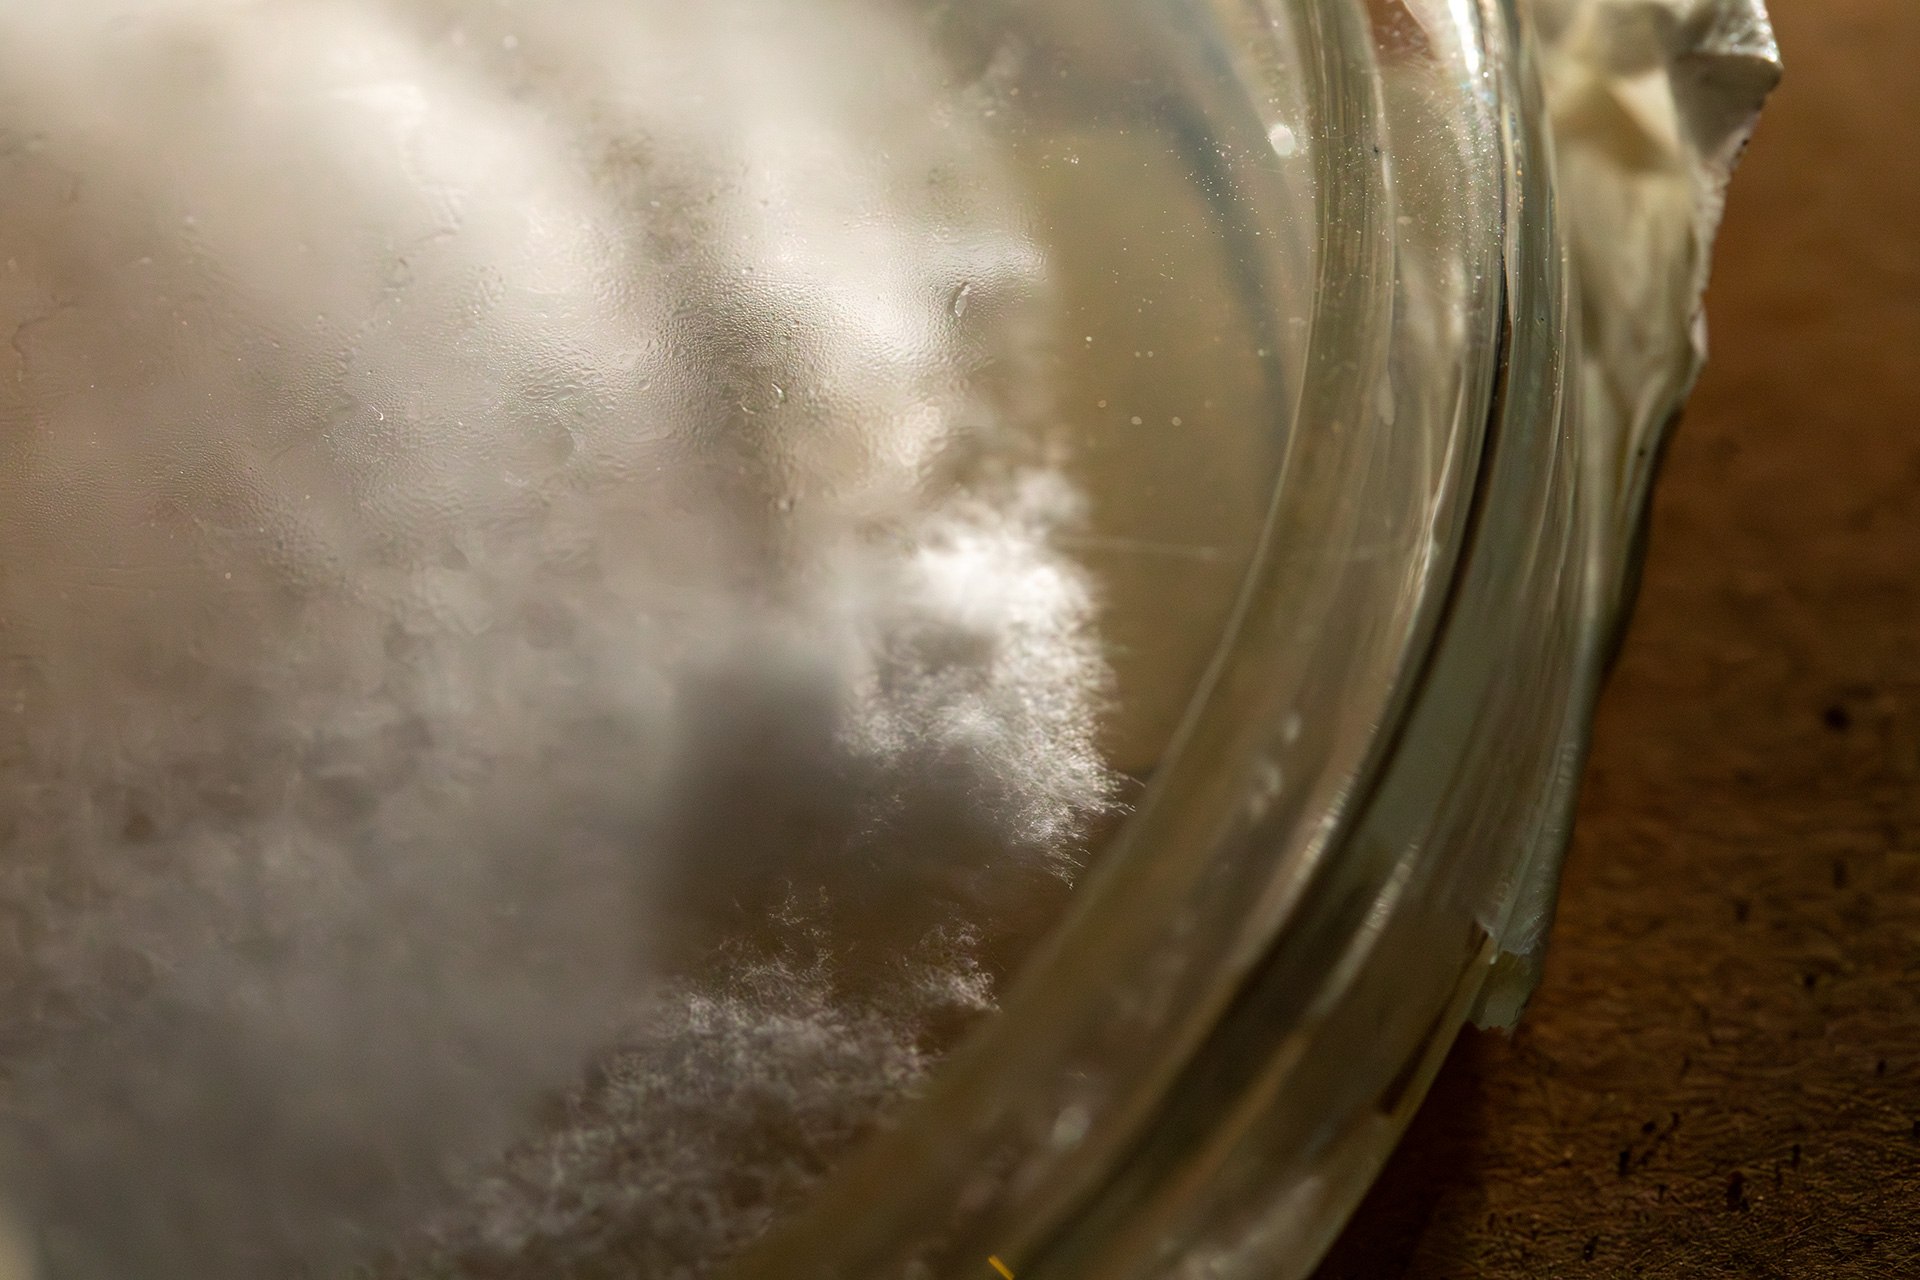
Close-up of a Petri dish containing white,fluffy mycelium growth on a transparent surface. The background is blurred, with a wooden tabletop partially visible.

Mycelium: Growing Networks
During our collaboration in 2024, Biplab prepares petri dishes to experiment with mycelium growth.
He shares: "The intricate growth of Reishi and Woodear mycelium in petri dishes offers a microscopic view of these networks, which are vital for nutrient exchange, soil health, and organic decomposition.
Reishi, often called the "Mushroom of Immortality", is renowned for its medicinal properties and ability to break down lignin. Similarly, Woodear mushrooms, prized for their jelly-like texture and health benefits, thrive on decaying wood, contributing to forest ecosystem balance."